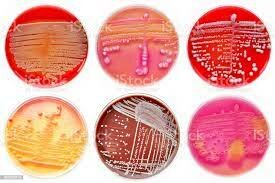
Richard Petri

-
 Fue la primera persona en describir los microorganismos en detalle, a los cuales denominó animáculos, presentes en agua de lluvia, fuentes, mar y nieve.
Fue la primera persona en describir los microorganismos en detalle, a los cuales denominó animáculos, presentes en agua de lluvia, fuentes, mar y nieve. -
 Descubrió la vacuna de la viruela, que tuvo trascendencia definitoria para combatir la viruela, enfermedad que se había convertido en una terrible epidemia en varios continentes.
Descubrió la vacuna de la viruela, que tuvo trascendencia definitoria para combatir la viruela, enfermedad que se había convertido en una terrible epidemia en varios continentes. -
 Desarrolló métodos para conservar alimentos en vidrio sellado botellas por calor en agua hirviendo
Desarrolló métodos para conservar alimentos en vidrio sellado botellas por calor en agua hirviendo -
 tenían teorías que reconocían la presencia de levaduras en la fermentación alcohólica, pero estas levaduras eran consideradas como compuestos químicos complejos, sin vida.
tenían teorías que reconocían la presencia de levaduras en la fermentación alcohólica, pero estas levaduras eran consideradas como compuestos químicos complejos, sin vida. -
 Comprobó que el tratamiento térmico repetido permitía evitar el crecimiento de microorganismos en infusiones. Supone un primer desarrollo de métodos de esterilización de líquidos.
Comprobó que el tratamiento térmico repetido permitía evitar el crecimiento de microorganismos en infusiones. Supone un primer desarrollo de métodos de esterilización de líquidos. -
 Realiza los primeros experimentos relacionados con la fermentación y la putrefacción originados por microorganismos.
Realiza los primeros experimentos relacionados con la fermentación y la putrefacción originados por microorganismos. -
 Realiza la memoria sobre la fermentación alcohólica
Realiza la memoria sobre la fermentación alcohólica -
 Descubrimiento del papel de levaduras en la fermentación
Descubrimiento del papel de levaduras en la fermentación -
 Realiza una serie de experimentos que demuestran el origen microbio de procesos de fermentación láctica, alcohólica, existencia de microorganismos anaerobios y demuestra que sólo puede producirse crecimiento microbio a partir de microorganismos preexistentes.
Realiza una serie de experimentos que demuestran el origen microbio de procesos de fermentación láctica, alcohólica, existencia de microorganismos anaerobios y demuestra que sólo puede producirse crecimiento microbio a partir de microorganismos preexistentes. -
 Afirmó que las diversas fermentaciones de la leche, así como la maduración de los quesos, eran causadas por hongos, y muchas otras investigaciones que derivaron en nuevas técnicas de conservación más efectivas y duraderas, como la refrigeración y congelación y tantas otras que hoy conocemos.
Afirmó que las diversas fermentaciones de la leche, así como la maduración de los quesos, eran causadas por hongos, y muchas otras investigaciones que derivaron en nuevas técnicas de conservación más efectivas y duraderas, como la refrigeración y congelación y tantas otras que hoy conocemos. -
 Desarrolla el principio de la asepsia en la práctica quirúrgica.
Desarrolla el principio de la asepsia en la práctica quirúrgica. -
 Desarrolla un método que permite la esterilización de líquidos que contienen esporas de bacilos
Desarrolla un método que permite la esterilización de líquidos que contienen esporas de bacilos -
 Inmunización, Pasteur utilizó las técnicas de Koch para aislar y cultivar la bacteria que causa el cólera en gallinas
Inmunización, Pasteur utilizó las técnicas de Koch para aislar y cultivar la bacteria que causa el cólera en gallinas -
 Realiza varios estudios sobre los agentes causantes de diversas enfermedades infecciosas.
Realiza varios estudios sobre los agentes causantes de diversas enfermedades infecciosas. -
 Desarrolla su método de tinción para las bacterias
Desarrolla su método de tinción para las bacterias -
introduce el uso de las placas Petri en Microbiología.
introduce el uso de las placas Petri en Microbiología. -
 Descubre que las bacterias que nodulan las leguminosas
Descubre que las bacterias que nodulan las leguminosas -
 Realiza los primeros estudios sobre los efectos geoquímicos producidos por bacterias.
Realiza los primeros estudios sobre los efectos geoquímicos producidos por bacterias. -
 describen el agente causante de la glosopeda (fiebre aftosa): aislamiento de virus animales
describen el agente causante de la glosopeda (fiebre aftosa): aislamiento de virus animales -
 AISLO EL PRIMER VIRUS VEGETAL (MOSAICO DEL TABACO)
AISLO EL PRIMER VIRUS VEGETAL (MOSAICO DEL TABACO) -
 El enlatado desarrollado en el siglo XIX terminó con las técnicas tradicionales de conservación de carnes como el salado, el ahumado, sino también ablandar sistemático de la carne de venado.
El enlatado desarrollado en el siglo XIX terminó con las técnicas tradicionales de conservación de carnes como el salado, el ahumado, sino también ablandar sistemático de la carne de venado. -
 desarrolla los primeros métodos quimioterápicos.
desarrolla los primeros métodos quimioterápicos. -
 Descubre el primer virus bacteriano (bacteriófago).
Descubre el primer virus bacteriano (bacteriófago). -
 Descubrió la penicilina. Este descubrimiento hizo posible la introducción de antibióticos que redujeron en gran medida el número de muertes por infección.
Descubrió la penicilina. Este descubrimiento hizo posible la introducción de antibióticos que redujeron en gran medida el número de muertes por infección. -
 Fue considerado como una ciencia aplicada principalmente involucrados en el control de la calidad microbiológica de los alimentos.
Fue considerado como una ciencia aplicada principalmente involucrados en el control de la calidad microbiológica de los alimentos. -
 Descubrieron el papel del DNA en la genética bacteriana
Descubrieron el papel del DNA en la genética bacteriana -

A list shows items. A timeline shows sequence.
Use Timetoast to make dates, milestones, and turning points easier to understand in a clear visual format. Timetoast is a timeline maker for work, school, research, and stories.